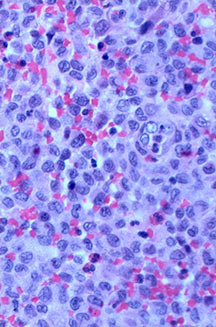

General Information
- This is a benign proliferation of Langerhans cells usually accompanied with eosinophils, lymphocytes, neutrophils and scattered plasma cells.
- There may be solitary or multiple lesions confined to bone
- 70% of cases consist of a solitary lesion
- Seldom leads to disseminated systemic disease
- Viewed as disorder of immune regulation or reactive process rather than neoplasm
- All organ systems may be affected with disseminated forms
- Hand-Schuller-Christian Disease (1-5 years): chronic disseminated histiocytosis
- Letterer-Siwe disease (<1 year): acute or subacute disseminated histiocytosis Uniformly fatal
- Solitary EG is twice as common as multifocal EG
- May arise from any bone and any site within a bone (epiphyseal, metaphyseal, diaphyseal)
- Radiographically variable appearance: may appear benign (geographic) or malignant (permeative or moth eaten)
Hand-Schuller-Christian Disease
Triad:
- Destructive skeletal lesions
- Exophthalmos
- Diabetes Insipidus
- 10% of patients with unifocal EG develop multifocal and extraskeletal disease
- Usually <5 years old
- Hepatosplenomegaly, adenopathy, anemia, fever, neurological complaints
- Fatal in 15%
- Any bone but 90% have skull involvement
Letterer-Siwe Disease
- Develops in 1st year of life
- Disseminated disease and small bone lesions
- Fatal in 95% who develop before 1 year of life
Clinical Presentation
Signs/Symptoms:
- Pain and soft tissue swelling
- Temporal bone disease is clinically indistinguishable from otitis media or mastoiditis
- May have a fever
- Mild peripheral eosinophilia (5%-10% of patients)
- Prevalence: Male predilection (2:1)
Age:
- 1 month – 71 years
- Most common age 5-15 years old
- 85% within first 3 decades
- 60% within first decade
Sites:
- Flat Bones (most common—70%)
- Skull
- Pelvis
- Femur
- Humerus
- Hands and Feet are rare in solitary disease
Radiographic Presentation


















Gross Pathology
- Gross appearance not distinctive
- Depending on mixture of cells, may be yellow, gray, or brown
- Older lesions are yellow due to regression and accumulation of lipid in histiocytes and Langerhans cells
- Intralesional hemorrhage exists
Microscopic Pathology
- Langerhans cell is diagnostic and clonal proliferation
- Nuclei show prominent nuclear groove (coffee-bean)
- Also composed of eosinophils and other inflammatory cells (non diagnostic component)
- Ratio of inflammatory cells to Langerhans cells varies
- Mitotic activity low
- Eosinophils dominate some areas forming diffuse sheets, excluding Langerhans cells
- Birbeck Granules: Electron Microscopy demonstrates granules that often take the form of a tennis raquet and form from complex invaginations of the cell membrane
- Vimentin, CD1 and S-100 positivity







Touch Prep of Langerhans Cells with Bean Shaped Nuclei

High power, Coffee Bean/Indented Nuclei of Langerhans Cells
Intermediate Power, Langerhans Cells Mixed with Eosinophils

Low Power, Langerhans Cells Mixed with Eosinophils

Eosinophils, Langerhans Cells Coffee Bean Indented Nucleus


Differential Diagnosis
- Osteomyelitis
- Granulomatous Inflammation
- Tuberculosis
- Fungus
- Hodgkin Disease
Biological Behavior
- Typically acts as a benign disorder
- Individual lesions may undergo partial or complete spontaneous resolution
- Patients with solitary lesions are at risk for developing additional bony lesions within 6 months to 2 years
- Adult patients with more than 3 bone lesions are at risk for visceral involvement although death due to EG in adults is rare
- Children with multiple bone lesions are at risk for visceral involvement that may cause death. Children less than 2 who develop disseminated disease are at highest risk for death
Treatment
- Majority of patients are cured by curettage or intralesional injection of a steroid
- Curettage and bone grafting for long bones and weight bearing bones at risk for fracture
- Intralesional steroids for non weightbearing bones
- Complete healing may take a year
- Low dose radiation may be valuable for inaccessible lesions
- Vertebral plana is braced and observed
Prognosis
- Complete healing after surgery may take 1 year
- Patients with intraosseous EG are at risk for developing additional lesions
- Pateints who develop additional bony lesions are at risk for organ involvement.
- Death is rare of adults, regardless of extend of lesions although children, especially when less than 2 years of age, more readily die from disseminated disease